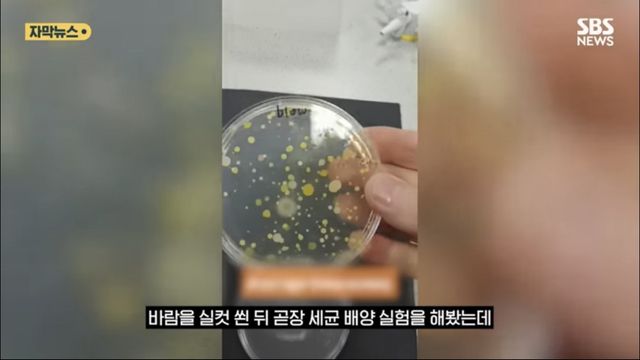
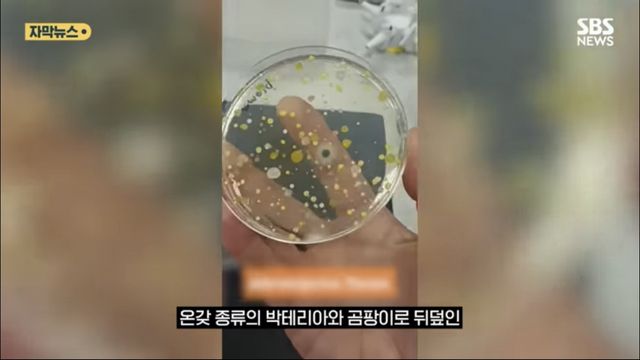
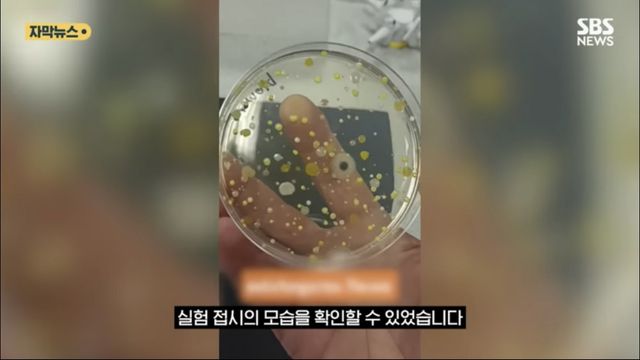
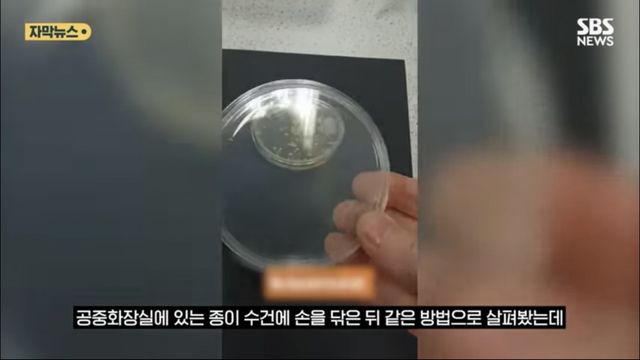
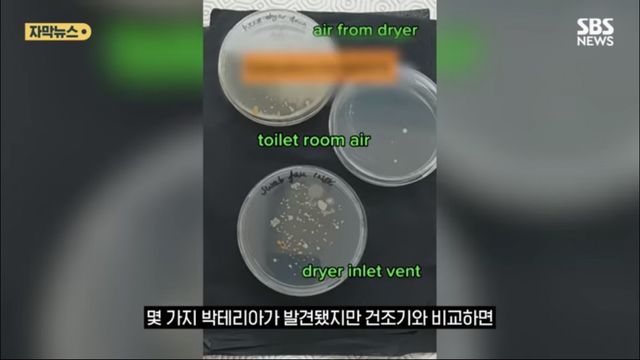
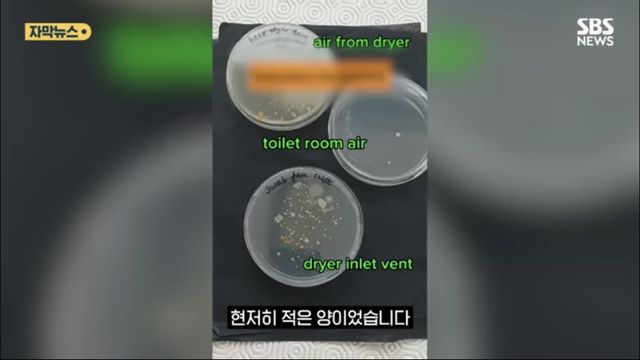
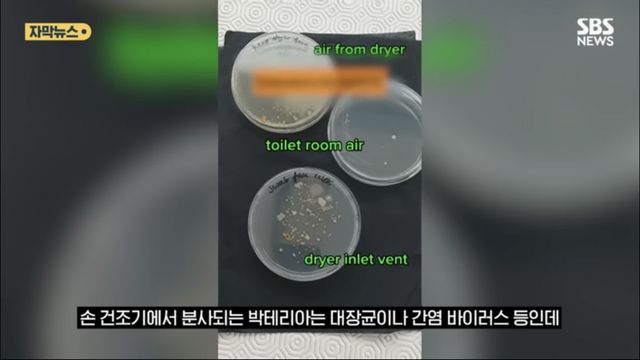

Copyright ⓒ 유머갤럭시 무단 전재 및 재배포 금지
본 콘텐츠는 뉴스픽 파트너스에서 공유된 콘텐츠입니다.
다음 내용이 궁금하다면?
광고 보고 계속 읽기
원치 않을 경우 뒤로가기를 눌러주세요

Copyright ⓒ 유머갤럭시 무단 전재 및 재배포 금지
본 콘텐츠는 뉴스픽 파트너스에서 공유된 콘텐츠입니다.